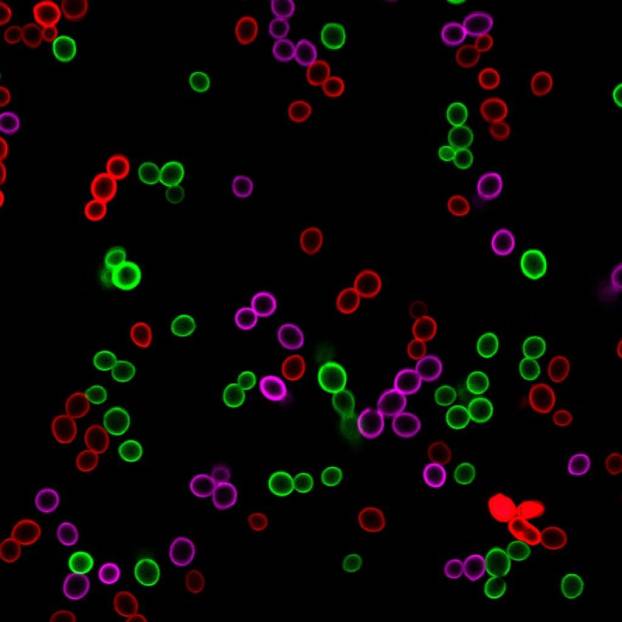

At Biotium, our specialty is creating fluorescent dyes that simplify and improve your scientific experiments. For Microbiology, we offer a wide range of fluorescent dyes and assays kits to stain bacteria, yeast and fungi, including dyes to assess cell viability and bacterial gram stain type. We have also developed a complete toolkit of reagents for viability PCR, a revolutionary method for determining microbial viability using qPCR.
Also visit our Cellular Stains Table for a comprehensive list of cellular stains with their ability to stain various cell types.
Bacterial Viability Stains
BactoView™ Dead Stains
- Highly Selective: Bright staining of dead cells with minimal background
- Compatible: Works with gram-positive and gram-negative strains
- Easy: Requires a single 30-minute staining step, no wash required
- Color Choice: Available in 7 colors from green to near-IR
BactoView™ Viability Kits
- Two-Color Staining: Label both live and dead bacteria
- Compatible: Works with gram-positive and gram-negative strains
- Easy: Requires a single 30-minute staining step, no wash required
- Two Kit Options: Choose from either a red or far-red BactoView™ Dead Stain
Improved Selectivity for Dead Gram-Positive Bacteria

Robust Visualization of Live & Dead Cells

BactoView™ Dead Stains & Viability Kits
| Product Name | Ex/Em (nm) | Detection Channel | Size (1000X in DMSO) | Catalog No. |
|---|---|---|---|---|
| BactoView™ Dead 500/515 | 497/515 | FITC | 20 uL | 40107-T |
| 100 uL | 40107 | |||
| BactoView™ Dead 560/570 | 559/570 | Rhodamine, PI, PE | 20 uL | 40108-T |
| 100 uL | 40108 | |||
| BactoView™ Dead 570/585 | 572/583 | Rhodamine, PI, PE | 20 uL | 40109-T |
| 100 uL | 40109 | |||
| BactoView™ Dead 600/615 | 603/613 | Texas Red® or PE-Texas Red® | 20 uL | 40110-T |
| 100 uL | 40110 | |||
| BactoView™ Dead 655/670 | 653/671 | Cy®5, APC | 20 uL | 40111-T |
| 100 uL | 40111 | |||
| BactoView™ Dead 690/710 | 683/707 | Cy®5.5 | 20 uL | 40112-T |
| 100 uL | 40112 | |||
| BactoView™ Dead 760/780 | 759/780 | Cy®7, APC-Cy®7 | 20 uL | 40113-T |
| 100 uL | 40113 | |||
| BactoView™ Viability Kit (Green/Red) | Green (498/522)/Red (572/583) | FITC (Green)/Rhodamine, PI, PE (Red) | 1 kit | 32019 |
| BactoView™ Viability Kit (Green/Far-Red) | Green (498/522)/Far-Red (653/671) | FITC (Green)/Cy®5, APC (Far-Red) | 1 kit | 32020 |
Other Bacterial Viability Stains & Kits
| Product Name | Features |
|---|---|
| Live-or-Dye™ Fixable Viability Staining Kits | • Fixable dead cell stains • Wide selection of colors • Useful for flow cytometry or microscopy |
| Live-or-Dye NucFix™ Red Staining Kit | • Fixable, DNA-binding dead cell stain • Works in gram-negative bacteria only • Stains dead cells red |
| RedDot™2 Far-Red DNA Dye | • Nuclear-specific dead cell stain • Stains dead cells with far-red fluorescence |
| Viability/Cytotoxicity Assay Kit | • Suitable for gram-negative bacteria only • Green fluorescent DMAO stains DNA in all bacteria • EthD-III stains gram-negative dead cells red |
| Bacterial Viability and Gram Stain Kit | • CF®488A WGA stains gram-positive cells green • EthDIII stains gram-negative dead cells red • DAPI stains alll cells blue |
| 5-Cyano-2,3-ditolyl tetrazolium chloride (CTC) | • Substrate for measuring bacterial respiratory activity • Healthy cells reduce CTC into an insoluble red fluorescent formazan product |
Live Bacterial Stains
Bright Staining of All Bacteria in Your Sample
Need to visualize all bacteria in your sample regardless of species or metabolic state? BactoView™ Live stains are unique cell-permeant, fluorogenic DNA-binding dyes designed for bright staining of live and dead, gram-positive and gram-negative bacteria. The dyes are suitable for both microscopy or flow cytometry and are available in green or red fluorescence.
Features
- Fluorescently label all bacteria in your sample
- Stains live and dead, gram-positive and gram-negative cells
- Stained cells can be detected by microscopy or flow cytometry
- Available in green or red fluorescence
BactoView™ Live Dyes
| Product Name | Ex/Em (nm) (with DNA) | Detection Channel | Size (500X in DMSO) | Catalog No. |
|---|---|---|---|---|
| BactoView™ Live Green | 500/520 | FITC | 20 uL | 40102-T |
| 100 uL | 40102 | |||
| BactoView™ Live Red | 572/675 | Cy®3 (microscopy) PE-Cy®5 (flow cytometry) | 20 uL | 40101-T |
| 100 uL | 40101 |
Optimized Staining of Endospores
BactoSpore™ stains were developed to tackle the challenge of endospore detection by offering bright staining of endospores as well as live and dead gram-positive and gram-negative bacteria. In B. subtilis, the dyes stain both vegetative cells and endospores and have been validated for detection by fluorescence microscopy and flow cytometry.
Features
- Optimized for staining endospores, unlike other bacterial detection reagents
- Validated for microscopy or flow cytometry
- BactoSpore™ 485/500 for membrane staining in the FITC channel
- BactoSpore™ 488/540 for nucleic acid staining in the FITC or PE channel
BactoSpore™ 485/500 Membrane Stain

BactoSpore™ 488/540 Nucleic Acid Stain

BactoSpore™ Bacterial Stains
| Product Name | Ex/Em (nm) | Detection Channel | Size | Catalog No. |
|---|---|---|---|---|
| BactoSpore™ 485/500 Membrane Stain, 500X in EtOH | 484/504 | FITC | 20 uL | 40119-T |
| 100 uL | 40119 | |||
| BactoSpore™ 488/540 Nucleic Acid Stain, 500X in DMSO | 488/536 (with DNA) | FITC or PE Channel | 20 uL | 40120-T |
| 100 uL | 40120 |
Other Available Dyes for Staining All Bacteria
Product Name | Features |
|---|---|
| RedDot™1 Far-Red DNA Dye | • Nucleic acid binding dye • Far-red fluorescence • Useful for fluorescence microscopy |
| DMAO, 2 mM in DMSO | • Green nucleic acid binding dye • Useful for fluorescence microscopy or flow cytometry |
| Hoechst 33342, 10 mg/mL in H2O | • Blue nucleic acid binding dye • Useful for fluorescence microscopy or flow cytometry |
| Thiazole Orange | • Nucleic acid binding dye • Green fluorescence • Useful for fluorescence microscopy or flow cytometry |
| CellBrite® Fix Membrane Stains | • Fixable membrane dyes • Green, red and far-red options • Useful for fluorescence microscopy |
| SynaptoGreen™ C4 | • Green fluorescent membrane dye • Useful for fluorescence microscopy |
| SynaptoRed™ C2 | • Red fluorescent membrane dye • Useful for fluorescence microscopy |
Bacterial Gram Stains
A traditional colorimetric gram staining protocol is laborious, requiring up to 5 different solutions to stain cells, including toxic alcohol and acetone to decolorize the sample, and precise timing. In contrast, Wheat Germ Agglutinin (WGA) has been shown to bind specifically to N-acetylglucosamine in the peptidoglycan layer of the cell wall of gram-positive bacteria, and can be labeled with a number of different fluorescent dyes for one-step fluorescent cell labeling. Our WGA conjugates feature bright and photostable CF® Dyes for rapid and sensitive staining of gram-positive bacteria. The WGA conjugates are available in 13 color options as well as combination kits that include counterstains for viability analysis or all bacteria.


Bacterial Gram Stains
| Product Name | Features |
|---|---|
| Wheat Germ Agglutinin (WGA) CF® Dye conjugates | • Fast and sensitive gram stains • Available in 13 colors |
| Live Bacterial Gram Stain Kit | • CF®594 WGA stains gram-positive cells red • DAPI stains all cells blue |
| Bacterial Viability and Gram Stain Kit | • CF®488A WGA stains gram-positive cells green • EthD-III stains dead cells red • DAPI stains all cells blue |
Yeast Viability Stains
Browse our selection of fluorescent dyes and kits validated for yeast viability analysis, including dyes to discriminate between live and dead cells, combination staining kits, and organelle stains. Also, learn about Viability PCR for rapid and sensitive assessment of viable yeast by qPCR.



| Product Name | Features |
|---|---|
| Live-or-Dye™ Fixable Viability Staining Kits | • Fixable dead cell stains • Choice of 8 fluorescent colors |
| Propidium Iodide | • Red dead cell stain • Not fixable |
| Ethidium Homodimer III (EthD-III) | • Far-red dead cell stain • Not fixable |
| RedDot™2 Far-Red Nuclear Stain | • Far-red, nuclear dead cell stain • Not fixable |
| NucSpot® 470 | • Green, nuclear dead cell stain • Not fixable |
| ViaVac™ Red/Green | • Yeast-specific vitality dye • stains the vacuole red in metabolically active cells |
| Yeast Live-or-Dye™ Fixable Live/Dead Staining Kit | • Thiazole Orange stains all cells green • Live-or-Dye™ 568/583 stains dead cells red • Fixable staining |
| Yeast Viability Staining Kit | • CF® Dye-labeled Concanavalin A (ConA) to label the cell walls of all cells • Live-or-Dye™ viability dye to label dead cells • Choose blue/green, green/red, or red/far-red color combinations |
| Yeast Vitality Staining Kit | • Calcofluor White labels all cell walls blue • ViaVac™ Red/Green stains the vacuole red in metabolically active cells |
Yeast Organelle Stains
A number of our organelle and cellular stains can be used to stain yeast cells. Browse our selection of stains below validated for labeling yeast vacuoles, cell walls, bud scars, cytoplasm, and more.
Organelle Stains for Yeast
| Product Name | Features |
|---|---|
| MitoView™ Dyes | • Mitochondrial dyes in five colors: • MitoView™ 633 is mitochondrial membrane potential-dependent |
| LysoView™ 540 & 633 | • Label vacuoles in live yeast cells • 2 LysoView dyes stain the yeast vacuole LysoView™ 540 & LysoView™ 633 |
| LipidSpot™ 488 | • Label vacuoles in live yeast cells • Stains intracellular membrane structures |
| Calcofluor White | • Blue fluorescent chitin stain stains cell walls • Strongly stains bud scars |
| CellBrite™ Fix | • Stains the cell membrane • Available in 3 dye colors • Staining is fixable |
| MemBrite™ Fix | • Stains the cell periphery • Available in 8 dye colors • Staining is fixable |
| CF® Dye Concanavalin A (Con A) Conjugates | • Con A lectin binds to a-mannopyranosyl and a-glucopyranosy in the cell wall of yeast and fungi • Available in 10 colors |
| CF® Dye Wheat Germ Agglutinin (WGA) Conjugates | • WGA lectin binds sialic acid and N-acetylglucosamine • Strongly labels bud scars • Available in 13 colors |
| Thiazole Orange | • Green nucleic acid binding dye • Can be used as an all-cell yeast stain • Staining in yeast is both nuclear and cytoplasmic in unfixed cells and cytoplasmic after fixation |
| NucSpot® 470 Nuclear Stain | • Green nucleic acid binding dye • Stains the nucleus of dead or fixed and permeabilized yeast |
| ViaFluor® CFSE | • Can be used as an all-cell cytoplasmic stain in yeast |
| Phalloidin conjugates | • Phalloidin stains F-actin cables and patches in fixed and permeabilized yeast • Available in 20 colors and biotin |
Cellular Stains in Different Organisms
The table below lists the application of several cellular stains for various organisms. A “Yes” indicates the stain is validated for the organism and may be used for reliable analysis. A “No” indicates that we do not recommend this stain for that organism; however some staining may still occur. See our FAQ for more information.
For most of the stains the following cell types were used:
Mammalian cells: HeLa
Yeast: Saccharomyces cerevisiae
Gram+ bacteria: Staphylococcus epidermidis
Gram- bacteria: E. coli
2 Internalizes to vacuolar membranes
3 Stains bud scars of budding yeast
4 Weak staining and not nuclear
5 Staining is not nuclear
6 Initially stains mitochondria, then redistributes to nucleus & cytoplasm
7 Dead cell specific but not nuclear
8 Stains live and dead cells
9 Not cytoplasmic, stains cell periphery
10 Staining is not lysosomal
11 Not predicted to bind yeast/bacteria cytoskeleton
12 Staining is both nuclear and cytoplasmic
FUN1 is a registered trademark of Thermo Fisher Scientific
Viability PCR with PMA & PMAXX™
Biotium is the inventor of the original viability PCR dye, PMA, and the new and improved viability PCR dye, PMAxx™. These photoreactive, membrane-impermeant, DNA binding dyes offer superior dead cell selectivity over traditional culture-based methods and the previous EMA (Ethidium Monoazide) v-PCR dye. We have also developed a large range of products and kits for viability PCR.
Learn more about viability PCR and our related products.
Introduction to viability PCR (v-PCR)
Viability PCR is a powerful technology for the sensitive and rapid detection of viable microorganisms. Unlike time-consuming culturing methods, qPCR is a fast and sensitive method of detection. However, normal qPCR does not distinguish between live and dead cells. With v-PCR using PMAxx™ or PMA, you get the speed, sensitivity and specificity of PCR, plus quantifiable viability. And because no culturing is required, you can even detect viable but not culturable (VBNC) bacteria. The v-PCR technology can be applied not only to bacteria but to other organisms like yeast, viruses, eukaryotes, and archaea.
How does v-PCR work?
The infographic below shows the basic mechanism of v-PCR. PMAxx™ and PMA are photoreactive dyes with high affinity for DNA. The dyes intercalate into dsDNA and form a covalent linkage upon exposure to intense visible light. The reaction inhibits PCR amplification of modified DNA templates by a combination of removal of modified DNA during purification and inhibition of template amplification by DNA polymerases. Because the dyes are cell membrane-impermeable, when a sample containing both live and dead bacteria is treated with dye, only dead bacteria with compromised cell membranes are susceptible to DNA modification. In a qPCR reaction, dead cell DNA will show delayed amplification and higher Ct than live cells.

PMA & PMAxx™ Dyes for Viability PCR
PMA is the original v-PCR dye developed at Biotium, validated in many bacterial strains, as well as yeast and viruses (see PMA References). PMA can differentiate live/dead bacteria by qPCR, but it does not completely eliminate PCR products from dead cell DNA, potentially giving false positive results.
PMAxx™ is more effective at eliminating PCR amplification of dead cell DNA, and thus provides the best discrimination between live/dead bacteria.

Other Viability PCR Reagents
Viability PCR Starter Kits
The customizable Viability PCR Starter Kits contain the materials that you need for selective detection of viable cells using either PMA or PMAxx™ viability dye and qPCR. You also have the choice of selecting a kit with or without the Enhancer for Gram Negative Bacteria (not to be used with other cell types). Please note, primers are not included and are required to amplify your species of interest.
| Product Name | Catalog No. | Viability Dye | Target Cell Type |
|---|---|---|---|
| Viability PCR Starter Kit with PMA | 31075 | PMA | Any cells |
| Viability PCR Starter Kit with PMAxx™ | 31075-X | PMAxx™ | Any cells |
| Viability PCR Starter Kit with PMA and Enhancer | 31076 | PMA | Gram-negative bacteria |
| Viability PCR Starter Kit with PMAxx™ and Enhancer | 31076-X | PMAxx™ | Gram-negative bacteria |
Strain-Specific Viability PCR Kits
Strain-specific v-PCR kits are designed for selective detection of viable bacteria from a specific strain using PMAxx or PMA dye and real-time PCR. The kits contain PMA dye or PMAxx™ dye, Forget-Me-Not™ EvaGreen® qPCR Master Mix, and validated PCR primers for detection of selected strains of bacteria.
Strain-Specific Bacterial Viability PCR Kits
| Bacteria Strain | Gene name | Kit with PMA (catalog #) | Kit with PMAxx™ (catalog #) |
|---|---|---|---|
| Salmonella enterica | invA | 31033 | 31033-X |
| Mycobacterium tuberculosis | groEL2 | 31034 | N/A |
| Staphylococcus aureus | nuc | 31035 | N/A |
| MRSA | mecA | 31036 | N/A |
| E. coli O157:H7 | Z3276 | 31037 | 31037-X |
| E. coli | uidA | 31050 | 31050-X |
| Listeria monocytogenes | hly | 31051 | 31051-X |
| Legionella pneumophila | mip | 31053 | N/A |













